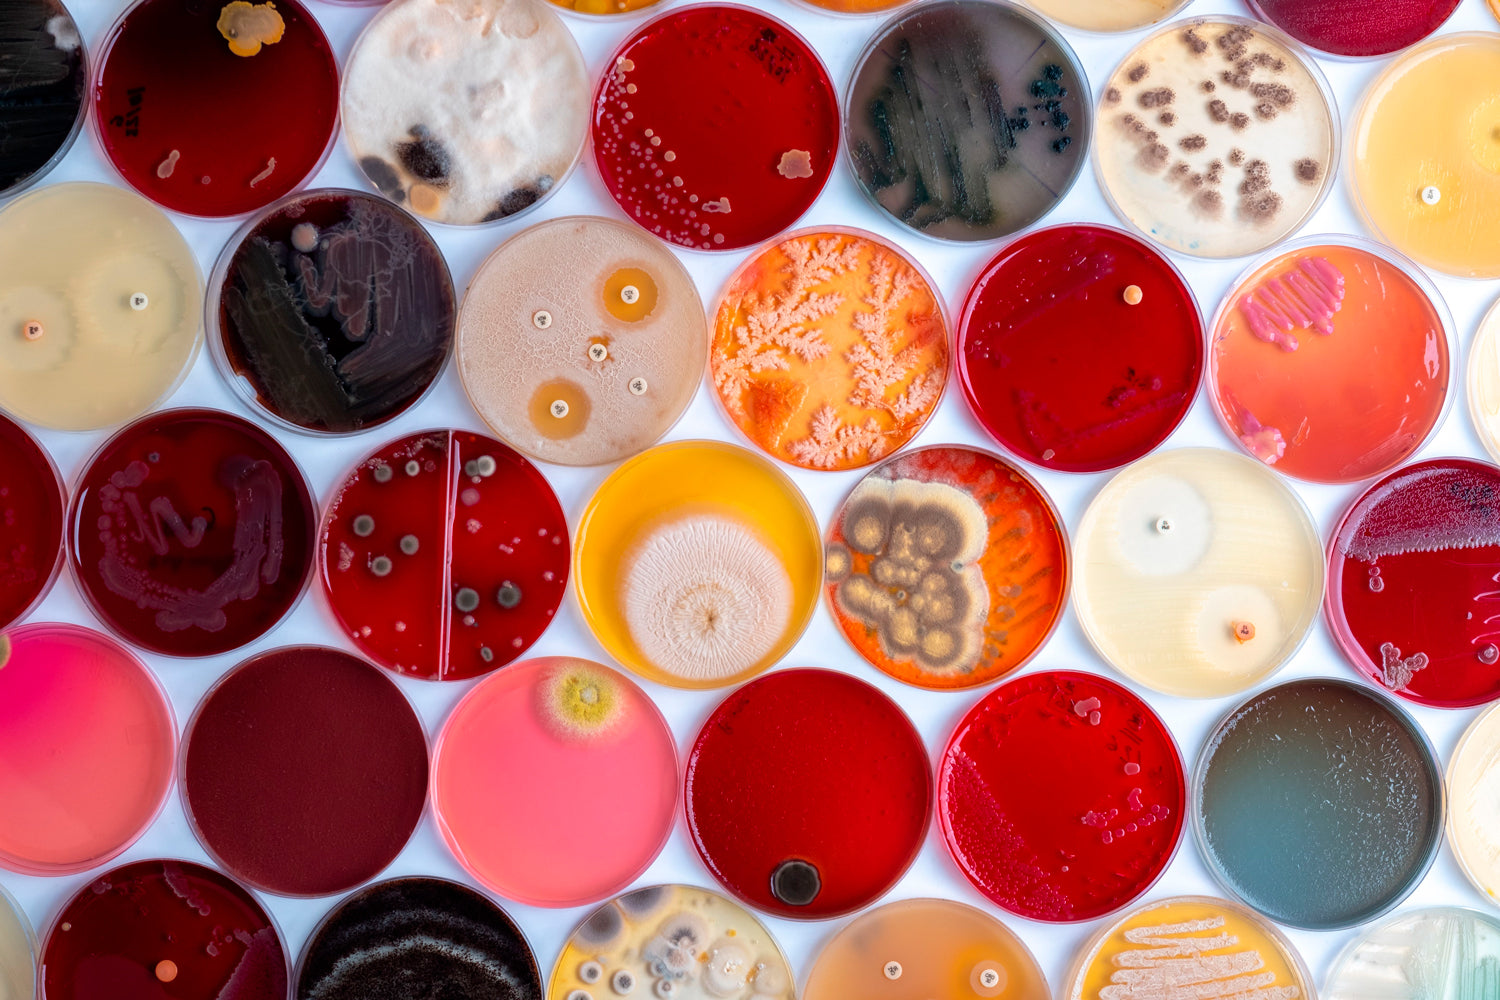

Asesoramiento Técnico
Brindamos asesoría técnica especializada orientada a maximizar la productividad y sostenibilidad de sus cultivos. Nuestro equipo de expertos le ayuda a seleccionar y aplicar las soluciones óptimas para impulsar el crecimiento y rendimiento de sus cultivos, garantizando resultados efectivos y respetuosos con el medio ambiente.

Análisis de Suelo
¿Por qué es importante realizar un análisis de suelo?
Un Análisis de Suelo te ayudará a prevenir el bajo rendimiento de tus tierras de cultivo. Son importantes para un correcto programa de fertilización, nos ayudan a conocer nuestro suelo y saber de qué nutrientes dispone para el cultivo.
Listado de Análisis

AGUA DIVERSOS USOS, OPCIONES ANALÍTICAS
- Agua de riego. Paquete completo A71
- Agua. Paquete microbiológico "Inocuidad"
- Agua. Paquete bacteriológico
- Agua de irrigación con conteo de bacterias
- Agua. Nutrientes en solución A-73 (Lisímetro)
- Agua. Paquete "Aptitud ganadera"
- Agua. Especial granjas avícolas
- Agua. Especial estanques piscícolas

ANÁLISIS FOLIAR, APLICACIONES Y OPCIONES ANALÍTICAS
- Agua de riego. Paquete completo A71
- Análisis Foliar. Perfil básico de Planta
- Análisis Foliar. Pruebas en Pecíolo
- Análisis Foliar. Prueba de Nitratos en tallo
- Análisis Foliar. Cultivos sensibles al Cloro
- Análisis Foliar. Cultivos sensibles al Molibdeno
- Análisis Foliar. Pruebas individuales.
- Otros Análisis en Plantas

BIOMASA MICROBIANA EN SUELO, OPCIONES ANALÍTICAS
- 1/. ENSAYO CUALITATIVO DE BIOMASA: Bacterias, hongos, protozoarios y nematodos. Los grupos de microorganismos se reportan de: No detectados, Detectados a Muy Altos.
- 2/. ENSAYO CUANTITATIVO DE BACTERIAS Y HONGOS ACTIVOS. Relaciones de biomasa en bacterias activas y totales; con relación a hongos activos y totales.
- 3/. PAQUETE BIOMASA MICROBIANA. Se reportan las cantidades activas de bacterias, hongos, de protozoarios y de nematodos. Estos últimos se enlistan por grupos funcionales. (Ver literatura sobre microorganismos)
- 4/. ANÁLISIS DE INOCUIDAD EN SUELO. (Paquete de 9 pruebas).
Salmonella spp, (NMP/4g); Escherichia Coli, (NMP/g); Coliformes fecales (NMP/g); Coliformes totales (NMP/g); E. Coli hemorrágico O157:H7 (NMP/g); Huevos de Helmintos (NMP/g); Shigella, (NMP/g); Listeria (NMP/g); Staphylococcus aureus.

COMPOSTAS, LOMBRICOSPOSTAS Y LIXIVIADOS, OPCIONES ANALÍTICAS
- Compostas. Perfil M5-Nutrientes en lixiviados
- Composta seca o granulada con Carbón y relaciones
- Composta seca. Solo Relación C/N
- Compostas secas o líquidas. Metales Pesados
- Compostas secas o líquidas. Perfil Ambiental
- Compostas Paquete Bacteriológico
- Compostas. Humificación y otros
- Compostas. Análisis microbiológicos de Inocuidad
- Compostas. Residuos de Plaguicidas y herbicidas

ESTIERCOLES, GUANOS Y MATERIAS PRIMAS ORGÁNICO,OPCIONES ANALÍTICAS
- Materias primas. Perfil M5 - Nutrientes
- Paquete Bacteriológico
- Materias primas. Perfil de 6 Metales Pesados
- Perfil Ambiental 10 Metales
- Materias minerales. Controles de calidad
- Pruebas microbiológicas de Inocuidad
- Análisis de fitopatógenos
- Análisis de fitobenéficos

FERTILIZANTES GRANULADOS, LÍQUIDOS Y MEZCLAS FÍSICAS, OPCIONES ANALÍTICAS
- Paquetes standard
- Paquete NP
- Paquete NPK
- Paquete PK
- Paquete NK
- Paquetes fertilizantes líquidos nitrogenados (UAN)
- Nitrato de Calcio
- Fertilizantes orgánicos, líquido o sólidos
- Enraizadores a base de NPK + S y diversos otros
- Extractos de algas marina. Abonos o bío-estimulantes
- Paquetes de Soluciones a base de azufre.
- Análisis Individual de Elementos

PLAGUICIDAS, PERFILES EN MATRICES, OPCIONES ANALÍTICAS
- Perfil agrícola de Residuos múltiples
- Perfil en Plantas, Agua y Suelo
- Perfil Frutas. Nivel de Máximo Residuo
- Perfil para Certificaciones Orgánicas
- Perfil Plaguicidas Halogenados
- Perfil Plaguicidas Organofosforados
- Perfil de Herbicidas a base de Triazina
- Perfil N-metil carbamatos
- Perfil Fungicidas a base de Thiocarbamatos
- Perfil herbicidas de Fenilurea
- Perfil Herbicidas ácido clorados.
- Análisis individuales y especiales

RESTAURACIÓN AMBIENTAL. BIORREMEDIACIÓN, OPCIONES ANALÍTICAS
- Agua de riego. Paquete completo A71
- Agua. Presencia de Trihalometanos
- Agua y Suelo. Plaguicidas organoclorados
- Agua, Presencia de hidrocarburos aromáticos
- Plaguicidas. Residuos en suelo, agua, planta. Precio
- Suelo. Caracterización de predios con riesgo. S3M-29
- Suelo. Biomasa microbiana; Salid del suelo

SUELO: ANÁLISIS QUÍMICO, FÍSICO Y DE SALINIDAD, OPCIONES ANALÍTICAS
- Fertilidad. Paquete químico de 23 Parámetros
- Paquete Químico y Físico. 27 Parámetros
- Paquete Sistemas de Riego. 29 Parámetros
- Fertilidad con Relación C/N. 32 Parámetros
- Salinidad del Suelo en Extracto de Pasta Saturada
- Relación C/N en Suelo (Individual)
- Indice de Estabilidad Biológica en suelo

SUSTRATOS PARA INVERNADERO. OPCIONES ANALÍTICAS
- Sustratos. Paquete S8A. Análisis completo
- Sustratos: Contenidos de N.P.K
- Sustratos. Solo Relación (C:N)
- Sustratos. Perfil de 6 Metales Pesados
- Perfil Ambiental: 10 Metales y metaloides
- Sustratos. Análisis individuales diversos
- Sustratos. Pruebas microbiológicas de Inocuidad
- Sustratos. Residuos de Plaguicidas y herbicidas

SERVICIOS PARA PRODUCTORES DE FRUTILLAS, OPCIONES ANALÍTICAS
- Fertilidad. Paquete químico de 23 Parámetros
- Análisis Tejidos Vegetales. (Análisis Foliares)
- Compostas polvo o granular. Relaciones entre elementos
- Análisis NPK en Fertilizantes y bioproductos
- Metales Pesados. En Fertilizantes, Suelo, Agua y Planta
- Biomasa microbiana del suelo
- Agua de riego. Paquete completo A71
- Análisis de Fitopatógenos

SERVICIOS ANALÍTICOS PARA PRODUCTORES DE MAÍZ
- Fertilidad del suelo. Paquete químico de 23 Parámetros
- Salinidad del Suelo en Extracto de Pasta Saturada
- Análisis Foliares en maíz. Hojas, tallo, raíces
- Análisis de Nitratos en el tallo de maíz
- Compostas polvo o granular. Relaciones entre elementos
- Análisis NPK en Fertilizantes, Suelo, Agua y planta
- Biomasa microbiana del suelo
- Agua de riego. Paquete completo A71
- Análisis de Fitopatógenos

Manejo de Residuos Orgánicos
El manejo integral de residuos orgánicos, como las compostas, es clave para evitar la emisión de gases de efecto invernadero y garantizar una descomposición óptima. Un tratamiento especializado transforma estos residuos en nutrientes aprovechables, mejorando la fertilidad del suelo y reduciendo el impacto ambiental.
Dado que los desechos porcinos pueden constituir un foco potencial de infecciones y una potencial fuente de contaminación atmosférica por las emisiones provocadas.Si no tenemos un correcto análisis de suelo tomaríamos decisiones sobre la fertilización, impidiendo conseguir los mejores resultados en la cosecha. Es importante realizar un análisis de suelos agrícolas, así como realizar un análisis del agua de riego.
Agua diversos usos, opciones analíticas
Compostas, lombricompostas y lixiviados, opciones analíticas
Microbiología, pruebas en varias matrices, opciones analíticas
Conoce la nueva línea GERMEN 2025
GERMEN RED ENERGY Bioestimulante Premium